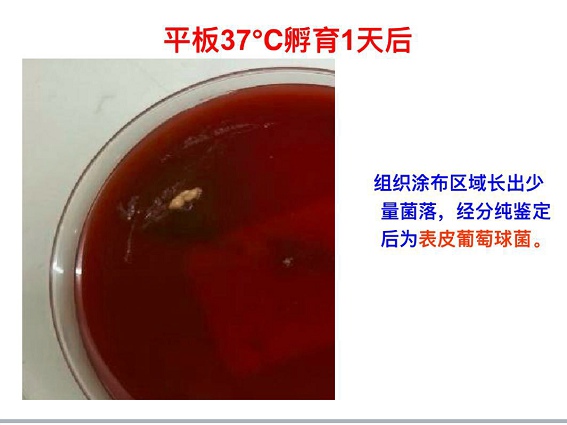
把胳膊砍掉疼不疼,医生能不能帮帮我

大伟走进我的小小诊室,第一句话就是:"医生,你们医院这么大,水平这么好,能不能把我这个胳膊砍掉?"。
这个五大三粗的壮汉操着浓重的方言,把厚厚一沓病历和一大卷片子拿到我的面前。从衣着和谈吐来看,不是经济很充裕的病人,衬衫袖口和领子都磨毛了,口袋里皱巴巴塞着一包蹩脚香烟。
5月的天气已经有点热,他脱下衣服露出胳膊的时候,诊间里弥漫起浓重的浊臭,馊、酸、恶臭。空气中的异味顿时让人无法呼吸。熏得我这样见惯糜烂伤口的"老感染科医生"都立刻戴起了口罩。
大伟把胳膊伸到我的眼前,整个左臂有好多个溃烂的伤口,腐败、流脓、恶臭、皮肤上有巨大纠结的疤痕,有层层的色素沉着,还有多个冒出脓液的窦道。一看就知道,这是一个绵延很久的慢性感染。

"4年了,这个胳膊是好不了了,谁把它砍掉,谁就是救了我的命!"大伟用正常的右手拨拉着4年间奔波于多家医院累积起来的厚厚的病历资料。
我点点头,把X片插到看片灯上,看疾病最初开始的源头。
大伟在4年之前出过一次车祸,左手臂骨折。做了内固定手术。从外伤以后开始,这条左臂就没有消停过:骨髓炎、溃烂、继续溃烂、窦道形成、反复流脓。
我这里,是他到过的第六家医院。从当地做手术的市级医院、到省级医院、到治疗外伤出名的部队医院、到全国知名的治疗骨科疾病的医院、到知名的中医治疗骨髓炎的医院、中间做过7次清创手术。如果计算抗菌药物的疗程的话,一堆门诊病历和出院病历粗略翻翻,已经不下20种药物。
4年间,带浓浊的臭味,带着永远不愈合的伤口,被人嫌恶、不能正常工作和生活。这个壮汉吃的苦,可想而知。难怪他对这条胳膊已经痛恨到了要除之而后快的程度。
大伟很明显,是个干体力活的粗人。辗转这么多医院,又治疗,又手术,其中花费的精力和金钱早已十分可观,想来是因为这条胳膊太困扰他的生活了。
我开出了住院单:"你先住院进去,我们再想想办法。"门诊的时间需要适当限制,花费在回溯病历上已经有很多时间了,所以我决定把他收进病房,再考虑治疗方案。
"我没有钱。"大伟大大咧咧地说:"如果快点找个医生,把我的胳膊砍掉,可能会便宜点吗?"
"不可能。"我斩钉截铁地回答他。我拉起他的衣服请他自己看。大伟的颈部和左侧胸壁也有明显的感染迹象,尤其是左侧的胸壁,红、肿、压痛明显是胳膊的炎症已经蔓延过来的表现。
"砍掉胳膊也没有用。"我斩钉截铁地回答大伟。
这个壮汉痛苦地挠挠头,显然心里已经知道这个结果。"这是我来的最后一家医院,如果还治不好,我死了算了。"他用和我一样斩钉截铁的语气说。
这种迁延长达4年的感染伤口,已经治疗过多次,能不能最终搞定非常依赖病原体的诊断。所以一进病房的第一天,病房的医生小陈就给大伟留了脓液培养。还在伤口清创的时候留下了一些坏死组织做培养。希望可以发现明确的病原体。
分枝杆菌、葡萄球菌、还有其他导致创面感染的病原体都有可能。培养的结果也未必就是致病菌,人的表皮和毛囊里本身有大量细菌。
所以感染科医生就像侦探,每天在可能和不可能中整理诊断思路。唯一可以肯定的是,无论哪种病原体,治疗的疗程都短不了。
"老板,血平板长菌落了,看上去像表皮葡萄球菌"。小陈在第二天查房的时候把刚得到的培养结果报给我。
我乜他一眼,小陈在感染科病房已经2年,已经颇有临床判断能力。我在等他说下去,果然,小陈接下去说:"我觉得致病菌的可能性不大,可以继续等等看,我觉得这么多抗菌药物打下来没有结果,耐药金黄色葡萄球菌的可能性最大。"
我颔首,这小子修得点道行了,对病原体的判断已经颇有心得。肯用心的年轻医生进步都快。
五大三粗的大伟傻呵呵地插进来问:"要等多久,我没有什么钱,快给我用药吧。"
小陈皱眉,问我:"经验性抗炎的方案,我觉得应该用利奈唑胺+利福平或者左氧氟沙星,可以吗?"
用药方案大伟听不懂,其实机灵的小陈在问我,需要至少3个月到半年的抗炎方案很花钱,这个时时刻刻担心着费用问题的体力劳动者,能不能承受10万元的治疗方案。治疗耐药金黄色葡萄球菌的药物,可不便宜呢!
"再等一等结果,4年都已经等了,不需要太着急这几天的方案。"我看看这个壮汉,叹口气。医生除了考虑技术问题,经济也是必不可少要考虑的问题,半途而废的抗炎方案一定不会成功,但是这份心还是我来抄吧,不要让这个大汉再烦恼了!
三天后,小陈查房的时候兴奋地对我说:"有结果了!罗氏培养基上看见菌落了,用16SrRNA分子鉴定报告的结果是巴西诺卡氏菌。"

"啊!老天帮大伟省钱了。"我对小陈笑笑说。
"我觉得这个对了!我已经把SMZ给他口服上去,应该会有效!"小陈看看大伟的胳膊,皱皱眉头。这股浓重的臭味这几天来一直困扰着病房的医护人员,没有病人愿意和大伟一间病房。旁边床位的病人都给熏跑了。连走廊里都闻得到淡淡的馊味。
针对已经明确的病原体的治疗,是最可以看到实际效果的治疗。
每天几块钱的SMZ,可以产生奇效吗?半年的SMZ大约只要2000多块钱。
"老板,都这样可以看好的话,医院好关门了!"小陈打趣我。
大伟这次没有啰嗦,一本正经地做个双手合十状。不知怎地看上去非常诚挚。
一周后,我来查房的时候,大伟正在打包准备出院。病房里那股浊臭淡了很多,他的左胳膊虽然仍旧累累伤口,但是已经不肿了。忽然瘪下去的皮肤不再红,不再肿的亮晶晶的。
"你救了我的命,等我好了,一定来好好谢谢你。"这个壮汉操着浓重的方言乐呵呵地拍拍我。他丝毫没有注意到一帮医生跟着我查房时站得规规矩矩的样子。
"不要断药,一个月之后,到我门诊来看。"有时候,这样的粗人也会很不听话,略见好就不好好吃药。我叮嘱大伟。
"遵命老板。"大概是听到研究生时时这样叫我,大伟的土话把"老板"两个字叫的非常滑稽地回答我。
后来,后来,我就把大伟忘记了。因为感染科始终在看这样一些疑难诊断、困难治疗的病人。我们的实验室,我们的感染科医生、影像科医生,都把现代的检验检查手段发挥到极致,才常常攻克一些人所不能的疑难疾病。我深知这绝非我一人所能。
大伟完成了疗程后,回到他自己正常的人生中去,消失在茫茫人海中,我也慢慢把他忘记了。继续为不同的感染病人纠结、诊治。
4年后,有一天,我去感染科病房查房,走廊里一股冲鼻的臭气传来。引得我立刻皱起了眉头。
"23床收了一个糖尿病足的老头,老板要么查一下房。"小陈似笑非笑地看看我。
"怎么把糖尿病足收感染科来,不会到骨科去会诊吗?!"糖尿病足虽然也算感染性疾病,但是大多数需要不断换药,清创、疏通血管、甚至植皮,需要骨科医生不停做外科处理才行。医院的常规流程就是收在骨科,感染科会诊。我颇为不满地问小陈:"谁收进来的?"。
"老板,你好啊!"一个怪腔怪调带着浓重土话的声音在我身后响起。待我回过头来,一个壮汉大力用手拍我的肩膀,也不管身后一群跟查房的医生站的规规矩矩的,象老朋友一样抱住我,抓住我的肩膀晃两晃。
大伟还是穿着一件领口和袖口都磨毛了的衬衫,口袋里还是皱巴巴地塞着一包烟。挥舞着两个膀子,乐呵呵地说:"你能看好我的绝症,就一定看得好我老爸的。世界上如果还有一个人能看好,就一定是你。"
我啼笑皆非地揪住他的左手看一看,那只手已经完全好了,留下几个纠结的疤痕,活动自如。他非常配合地摆一个健美先生的姿势嘚瑟一下。
小陈冲我摊摊手:"老板,他说一定要你看,非你不可,不到你这里他就跟我没完。"
"好吧"。我拍拍大伟,象安慰一个小孩子一样请他稍安勿躁,快点闭嘴,免得身后跟的一群查房的医生忍笑忍得肚子痛。
一个医生,就是一个医生,不管千难万险,多少疑难和困扰,最无法拒绝的就是这样毫无条件,毫无保留的相信。或许这是医生这个职业最让人不能拒绝的成就感。
即使你知道自己并非无所不能,这样赤城的信任也会让你竭尽所能。
